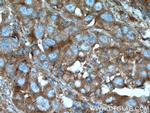
B4GALT3 Antibody in Immunohistochemistry (Paraffin) (IHC (P))

Search
Proteintech
B4GALT3 Polyclonal Antibody
{{$productOrderCtrl.translations['antibody.pdp.commerceCard.promotion.promotions']}}
{{$productOrderCtrl.translations['antibody.pdp.commerceCard.promotion.viewpromo']}}
{{$productOrderCtrl.translations['antibody.pdp.commerceCard.promotion.promocode']}}: {{promo.promoCode}} {{promo.promoTitle}} {{promo.promoDescription}}. {{$productOrderCtrl.translations['antibody.pdp.commerceCard.promotion.learnmore']}}
产品信息
11041-1-AP
种属反应
已发表种属
宿主/亚型
分类
类型
抗原
偶联物
形式
浓度
规格
纯化类型
保存液
内含物
保存条件
运输条件
产品详细信息
Immunogen sequence: MLRRLLERP CTLALLVGSQ LAVMMYLSLG GFRSLSALFG RDQGPTFDYS HPRDVYSNLS HLPGAPGGPP APQGLPYCPE RSPLLVGPVS VSFSPVPSLA EIVERNPRVE PGGRYRPAGC EPRSRTAIIV PHRAREHHLR LLLYHLHPFL QRQQLAYGIY VIHQAGNGTF NRAKLLNVGV REALRDEEWD CLFLHDVDLL PENDHNLYVC DPRGPRHVAV AMNKFGYSLP YPQYFGGVSA LTPDQYLKMN GFPNEYWGWG GEDDDIATRV RLAGMKISRP PTSVGHYKMV KHRGDKGNEE NPHRFDLLVR TQNSWTQDGM NS (1-321 aa encoded by BC009985)
靶标信息
The beta-1,3 galactosyltransferase( beta3GalT) gene family encodes a set of type II transmembrane glycoproteins that are catalytically diverse and use different donor substrates (UDP-galactose and UDP-N-acetylglucosamine) and different acceptor sugars (N-acetylglucosamine, galactose, N-acetylgalactosamine ) to catalyze the addition of an activated monosaccharide to a terminal lactose. The protein coding sequences for beta-1,3-Gal-T genes comprise a single exon and are distantly related to the Drosophila Brainiac gene. The beta-1,4-galactosyltransferase ( beta4GalT) gene family encodes type II membrane-bound glycoproteins that show exclusive specificity for the donor substrate, UDP-galactose. beta-1,4Gal-T genes transfer galactose in a beta-1,4 linkage to similar acceptor.
仅用于科研。不用于诊断过程。未经明确授权不得转售。
生物信息学
蛋白别名: b4Gal-T3; Beta-1,4-galactosyltransferase 3; Beta-1,4-GalTase 3; Beta-N-acetylglucosaminyl-glycolipid beta-1,4-galactosyltransferase; beta-N-acetylglucosaminyl-glycolipid beta-1,4-galactosyltransferase 3; Beta-N-acetylglucosaminyl-glycolipid4-galactosyltransferase; Beta-N-acetylglucosaminylglycopeptide beta-1,4-galactosyltransferase; Beta-N-acetylglucosaminylglycopeptide4-galactosyltransferase; epididymis secretory sperm binding protein; N-acetyllactosamine synthase; Nal synthase; Neolactotriaosylceramide beta-1,4-galactosyltransferase; UDP-Gal:beta-GlcNAc beta-1,4-galactosyltransferase 3; UDP-Gal:betaGlcNAc beta 1,4- galactosyltransferase, polypeptide 3; UDP-galactose:beta-N-acetylglucosamine; UDP-galactose:beta-N-acetylglucosamine beta-1,4-galactosyltransferase 3; unnamed protein product
基因别名: B4GALT3; beta4Gal-T3
UniProt ID: (Human) O60512
Entrez Gene ID: (Human) 8703